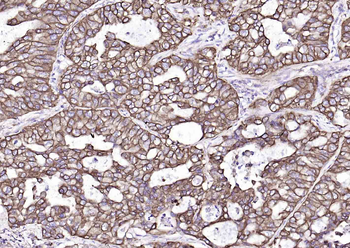

You have no items in your shopping cart.
Cart summary

KRT19 Antibody
Catalog Number: orb239626
| Catalog Number | orb239626 |
|---|---|
| Category | Antibodies |
| Description | KRT19 Antibody |
| Species/Host | Rabbit |
| Clonality | Polyclonal |
| Tested applications | ELISA |
| Reactivity | Human |
| Isotype | IgG |
| Immunogen | Recombinant Human Keratin, type I cytoskeletal 19 protein (334-400AA) |
| Form/Appearance | Liquid |
| Conjugation | Unconjugated |
| Target | KRT19 |
| UniProt ID | P08727 |
| Storage | Maintain refrigerated at 2-8°C for up to 2 weeks. For long term storage store at -20°C in small aliquots to prevent freeze-thaw cycles. |
| Buffer/Preservatives | Preservative: 0.03% Proclin 300. Constituents: 50% Glycerol |
| Alternative names | anti Cytokeratin-19 antibody, anti Keratin-19. KRT Read more... |
| Note | For research use only |
| Expiration Date | 12 months from date of receipt. |
Anti-Cytokeratin 19/KRT19 Antibody [orb316578]
FC, ICC, IF, IHC, WB
Human, Mouse, Rat
Rabbit
Polyclonal
Unconjugated
10 μg, 100 μgCytokeratin 19 Mouse Monoclonal Antibody [orb500700]
ICC, IF, IHC-Fr, IHC-P, WB
Mouse
Human, Mouse, Rat
Mouse
Monoclonal
Unconjugated
200 μl, 100 μl, 50 μlKRT19 Antibody / Cytokeratin 19 [orb749642]
IF, IHC-P, WB
Human, Rat
Mouse
Monoclonal
Unconjugated
20 μgKRT19 Antibody / Cytokeratin 19 [orb2638790]
IF, IHC-P, WB
Human, Rat
Mouse
Monoclonal
Unconjugated
100 μgCytokeratin 19 Rabbit Polyclonal Antibody [orb5872]
FC, IF, IHC-Fr, IHC-P, WB
Bovine, Canine, Equine, Gallus, Mouse, Porcine, Rabbit, Rat
Human
Rabbit
Polyclonal
Unconjugated
200 μl, 50 μl, 100 μl